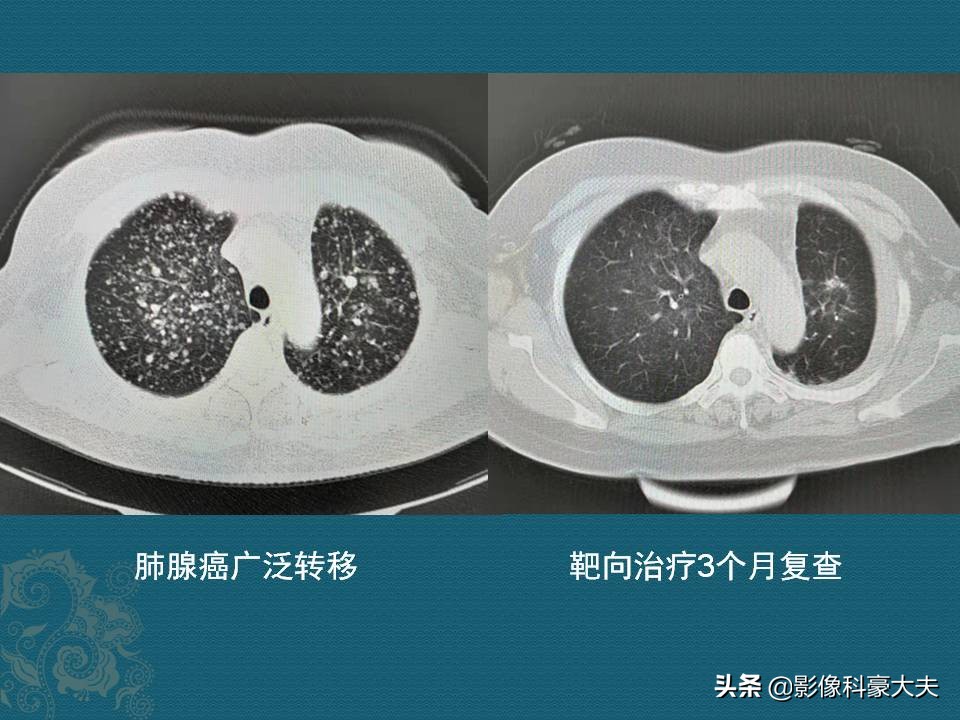
查出癌症后别绝望,癌症保守治疗的最新治疗方法

喜欢看豪大夫科普的读者朋友,可能会发现豪大夫一个特点:喜欢报喜,不喜报忧。大家看得没错,豪大夫性子偏软,不适合当独当一面的主刀医生。
一晃很多年了,遇到肺癌发生转移的病人,豪大夫就会想起一位河南的老人,一位放弃治疗的晚期肺癌病人……
他说,闺女啊,我得了什么病?要是严重的病我就不治了
这位70多岁的老人,是胸闷憋气半年,逐渐加重,去河南嵩县某医院做了CT:

这是另一位类似的病人
双肺密密麻麻的结节灶,圆而光滑,快长满双肺了,这是典型的肺转移癌,没有根治机会了。
这是豪大夫在医生群里参与会诊的病例,河南那位女医生很心酸地介绍说,老人穿得很朴素,等待诊断报告的时候,老人问她:闺女啊,我这病严重不?要是癌,我就不治了!我自己也觉得不大好,快上不来气儿了……
那个时候,一二代的靶向药也很贵,一年要十万加,老人也承受不起。后来就再也没有回来……
地球在转,时代在变,科技可以改变生活
下图是一位55岁的女士,胸闷喘憋1个月,CT发现肺腺癌多发转移:
左图可以看到,双肺密密麻麻的粟粒状小结节状转移瘤,有上万颗,无法手术了。幸运的基因检测阳性,靶向治疗3个月复查,转移瘤都消散了,症状解除。
这种情况目前还无法根治,只能延长生存期。有些幸运的病人,仅依靠一二代靶向药也能坚持3年以上,这些药进医保了,普通家庭也可以承受。除了靶向治疗之外,如果是数量较少的实性转移瘤,还可以做射频消融术、放射性粒子植入等,延长寿命甚至长期带癌生存。
如果那位河南的老人现在还在,就有药可医了……
癌症病人,尤其是中晚期失去手术机会的病人,不要轻易放弃希望,现在网络交流便利,新的治疗方法也传播很快,去正规医院打听一下,或者在网络上找一些正规医院的肿瘤科医生咨询,量力而行,能延长寿命也是好的!下图这位老爷子,周围型肺鳞癌,通过植入放射性粒子,已经3年多了:

最后还有一句不中听的题外话,年轻力壮的时候多攒点钱,自己保管或者交给老伴,别撒手,很多时候儿女未必靠得住!家家都有难念的经,医院是检验人性的地方,有些儿女,连几千块都不舍得掏……

豪大夫喜欢搜集治疗效果卓著的病例分享给大家,就是希望能帮助提升治疗信心,保持一个好心情!分享小病例,传递正能量!
#我心中难忘的医生/患者# #清风计划#